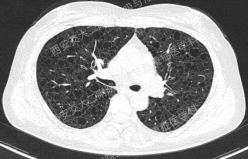

电话:029-87679000(总机)
地址:陕西省西安市西五路157号
邮编:710114
网址:www.2yuan.xjtu.edu.cn

电话:029-87679000(总机)
地址:陕西省西安市西五路157号
邮编:710114
网址:www.2yuan.xjtu.edu.cn

影像方寸藏玄机,同影异病辨真章。上期3例弥漫性囊性肺疾病引发了大家的广泛关注,后台留言刷屏,引发热议。但疾病诊治中的鉴别诊断、细节把控及治疗方案仍需进一步细化,让我们一起析病寻踪,深挖疾病真相,共探诊疗核心!
析病寻踪
Case 1

上图所示肺部囊性病变,双侧多发、大小不一,壁薄,形状不规则,呈圆形及扁平状为主,部分融合,分布多在纵隔胸膜下。入院后查血尿粪常规、肝肾功能电解质、凝血功能、血糖血脂心肌酶、BNP、肌钙蛋白正常;红细胞沉降率23mm/h,PCT、CRP正常;TB-spot阳性(阳性对照管反应水平123.49 pg/mL),TB-DNA、PPD试验、痰X-pert、痰涂片、痰培养均阴性;女性肿瘤标志物全套未见异常;结缔组织病相关指标:自身抗体ANA 1:100、CENP B阳性,CCP抗体25.1U/ml(正常参考值<17U/ml),ANCA、抗核抗体谱、体液免疫全套均阴性;血气分析大致正常,肺功能检查: FEV1占预计值78.2%,FEV1/FVC 69.55%,RV/TLC 49.62%,支气管舒张试验阴性,FeNO50 29.2ppb。
患者无吸烟史,二手烟接触不多。追问家族史,父母已故(具体不详),兄弟姐妹6人,大姐有肺大泡病史,未具体诊治,育有2子,均体健。进一步行双肾CT平扫提示双肾轻度积水,进一步行全外显子基因检测,回报FLCN突变:

该例患者BHD诊断明确,无皮肤及肾脏受累,仅表现为多发囊性肺病变。建议忌烟,避免受凉、劳累及剧烈运动,防范气胸。鉴于肺功异常,建议每年复查1次胸部CT及肺功能检查;每3年筛查1次肾脏MRI。同时建议其兄弟姐妹及其子完善症状前FLCN基因检测。






Case 2

上图所示肺部多发囊性病变,双肺广泛分布,直径在2-10mm之间,壁薄,囊壁间组织相对正常。结合育龄期女性等临床资料,不难诊断淋巴管平滑肌瘤病(LAM)。对疑似LAM的女性的初步评估还应包括血管平滑肌脂肪瘤的筛查、淋巴管受累以及是否存在未被诊断的结节性硬化症。该例患者经评估后诊断散发型S-LAM。


该患者肺功能下降达到治疗标准,但患者及家属暂不考虑用药,选择观察,目前随访中。曾咨询乘飞机到拉萨的问题,鉴于症状稳定,可乘坐飞机,但不建议上高原。
Case 3



上图与Case 2比较相似,所以诊断LAM没有问题,还需进一步排查系散发型还是结节性硬化症累及。



影像学评估发现患者多系统受累(肝脏错构瘤、双肾血管平滑肌脂肪瘤、颅脑多发异常信号结节)。追问病史,患者本人无皮疹、癫痫及智力低下;患者儿子有面部皮脂腺瘤,无癫痫及智力低下,胸腹部CT未见异常,皮肤科已确诊结节性硬化症;患者女儿面容及智力均正常;建议患者进一步行TSC基因检测,结果回报TSC2突变,结节性硬化症诊断明确。

患者尝试口服西罗莫司2mg/日,消化道难以耐受,减至1mg/日,仍有恶心等不适,自行停药,不愿再尝试药物治疗,目前随访观察中。




上述3个病例均为弥漫性囊性肺疾病,鉴别至关重要。

温故知新
以下2例不同患者的胸部影像改变,又分别考虑什么疾病呢?

